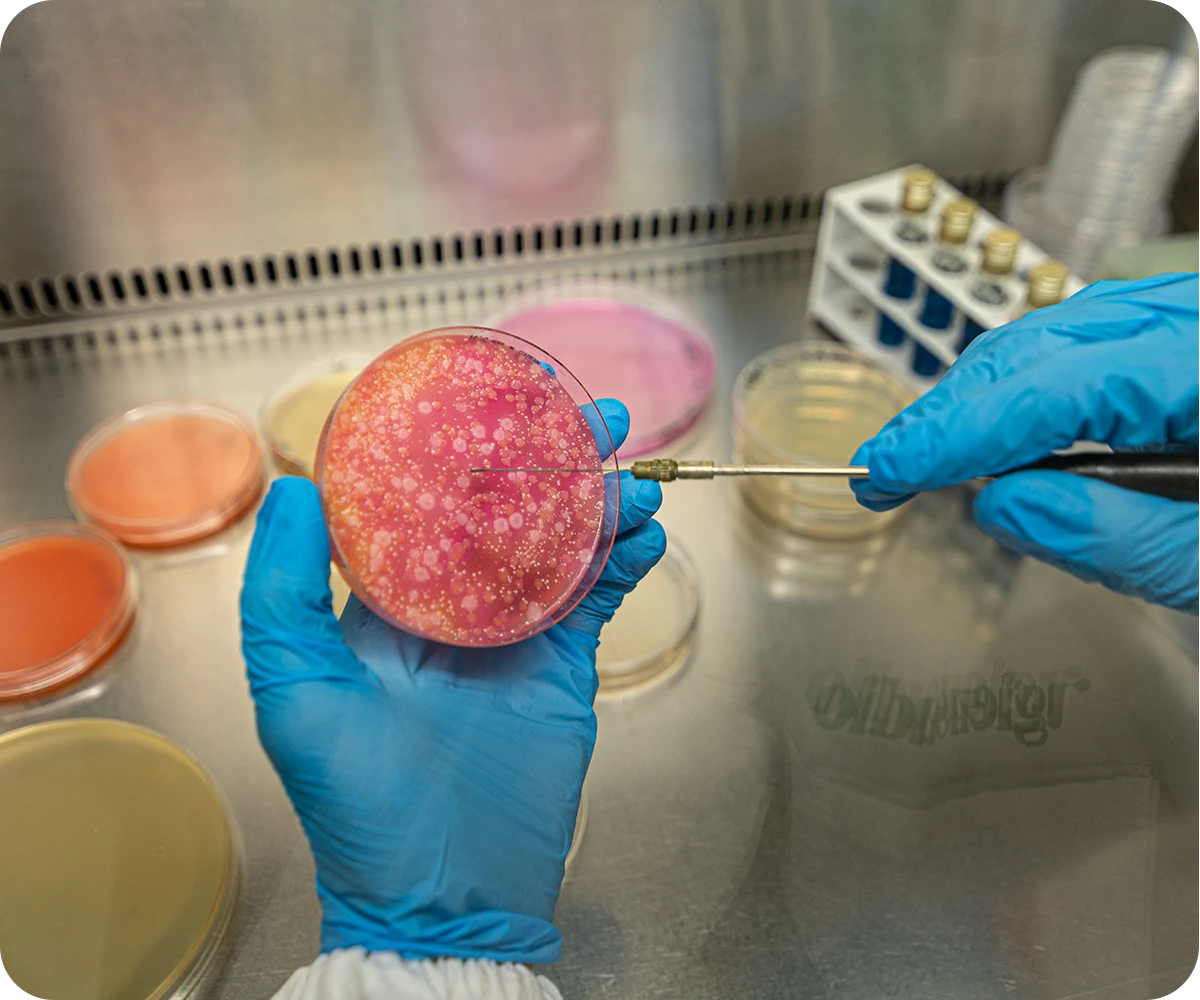

Igiene Alimentare
Regole comunitarie sull’igiene e sul controllo degli alimenti. La nostra consulenza in materia igienico sanitaria e di autocontrollo.
Dei criteri uniformi
Con l’entrata in vigore del cosiddetto “Pacchetto Igiene”, il 1° gennaio 2006, sono cambiate definitivamente le regole comunitarie sull’igiene e sul controllo ufficiale degli alimenti. Con i Regolamenti facenti capo al “Pacchetto igiene” (Reg. Ce 852, 853, 854, 882/2004) direttamente applicabile da tutti gli Stati Membri, sono stati individuati criteri uniformi riguardo l’igiene della produzione degli alimenti: i controlli di natura sanitaria, conseguentemente, sono effettuati secondo i medesimi standard su tutto il territorio dell’Unione Europea.
Tale uniformità ha reso così possibile la libera circolazione di alimenti sicuri contribuendo in maniera significativa al benessere dei cittadini, nonché ai loro interessi sociali ed economici. Tra i Regolamenti del pacchetto igiene troviamo il Regolamento CE 852/04 “sull’igiene dei prodotti alimentari che subentra al D.Lgs 155/1997 il quale aveva introdotto l’obbligo di definire ed attuare, nelle diverse attività della catena alimentare (deposito, preparazione, confezionamento, trasporto, distribuzione e vendita) procedure basate sul metodo HACCP.

Consulenza in materia igienico sanitaria
La nostra consulenza in materia igienico sanitaria e di autocontrollo viene fornita da personale tecnico qualificato, in grado di fornire un valido supporto alle aziende alimentari nell’adempimento delle seguenti attività.
- Approfondimenti sulla normativa applicabile nei diversi settori alimentari;
- Predisposizione della NIA Sanitaria (Notifica Inizio Attività – art. 6 del Reg. CE 852/04);
- Predisposizione della documentazione per l’ottenimento del riconoscimento comunitario, in base al Reg. CE 853/04, per la produzione e commercializzazione dei prodotti di origine animale;
- Predisposizione del documento di autocontrollo basato sul metodo H.A.C.C.P;
- Verifica e riesame periodico del documento di autocontrollo e della documentazione correlata;

- Predisposizione delle procedure di rintracciabilità degli alimenti in conformità al Reg. CE 178/02;
- Audit di seconda parte c/o aziende alimentari;
- Consulenza in materia di etichettatura degli alimenti (Reg. CE 1169/11);
- Campionamento ed analisi microbiologiche e chimiche degli alimenti secondo quanto stabilito dalla normativa vigente in campo alimentare (Reg. CE 2073/04 e s.m.i., Reg. CE 915/2023, …);
- Analisi chimica/microbiologica dell’acqua destinata al consumo umano in conformità al D.Lgs 18/23;
- Corsi di formazione rivolti agli addetti che operano nel settore alimentare.
